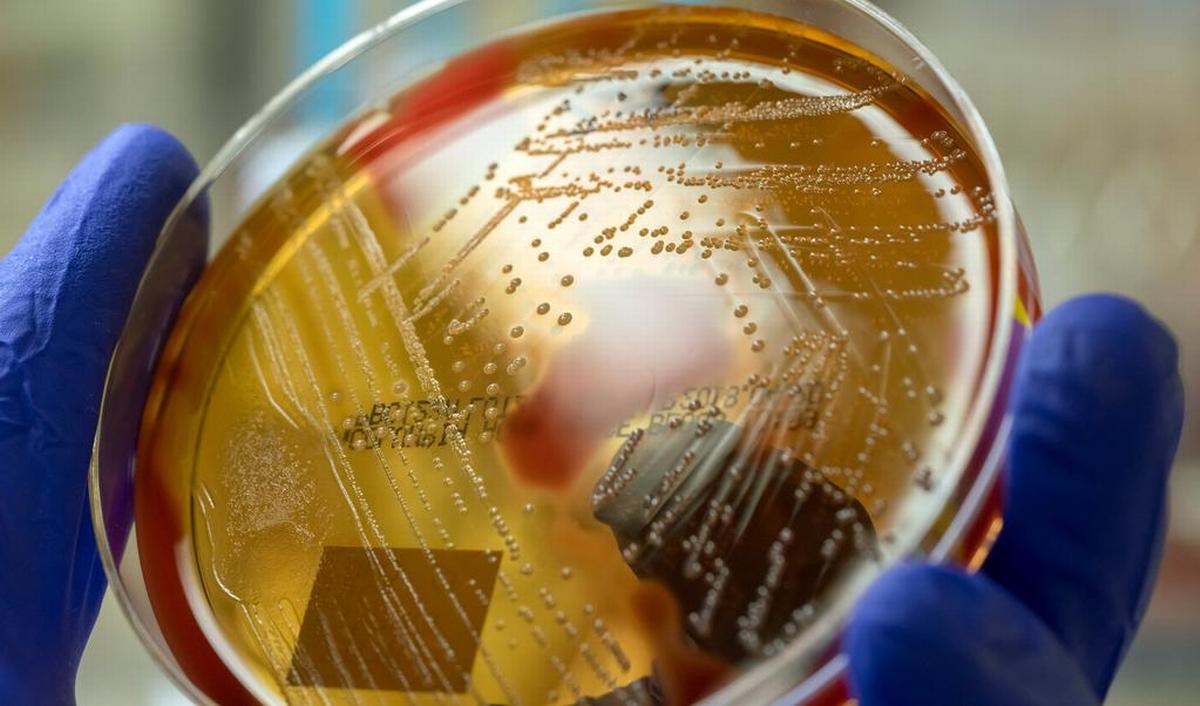
Hoe gevaarlijk zijn infecties met streptokokken

Streptokokken b hoe kom je eraan? Deze bacterie zit vaak in de normale vaginale flora of darmflora van vrouwen. Dit is bij 1 op de 5 vrouwen het geval. De vrouwen die GBS bij zich dragen hebben hier meestal geen klachten van. In soms kunnen er wel klachten ontstaan wanneer de GBS een blaasontsteking tijdens jouw zwangerschap veroorzaakt.. Bij een verwonding kunnen de A-streptokokken verschillende infecties veroorzaken, zoals infecties aan de nieren, de hersenvliezen, de hartkleppen en de baarmoeder (na de bevalling). De bacterie kan de spieren en de pezen in een korte tijd ernstig beschadigen. Om deze reden wordt de A-streptokok ook wel de vleesetende bacterie genoemd.

Prospekt Streptokokken B

AST en antiDNAseB (streptokokken serologie)

Streptokokken & StreptokokkenInfektion Arten, Symptome, Behandlung

GroepB streptokokken Zwangerschapspagina

Nach Ausbruch von AStreptokokken an Schule Auf diese Symptome müssen Eltern achten

StreptokokkenInfektion NetDoktor.at

Streptokokken BTest, 20 Kassettenteste/Pack, Abstrich, Diagn. Nord » PHARO e.K.

BStreptokokken · MDI Limbach Berlin

Woher bekommt man B Streptokokken Wir Eltern

Wat zijn streptokokken? En hoe herken je een infectie?

Steeds meer gevallen van besmettelijke streptokokken wat is de oorzaak en hoe behandel je het

Team Forschung HelmholtzZentrum für Infektionsforschung

Streptococcus Throat

Streptokokken B Gefahr für das Baby, Infektion, Vorbeugen Familienleben.ch

Group B streptococcus screening BabyCenter
Hoe gevaarlijk zijn infecties met streptokokken groep A (GAS) en groep B (GBS)? gezondheid.be

Streptokokken eine bakterielle Infektion während der Schwangerschaft.

BStreptokokkenScreening am Ende der Schwangerschaft • Labor Enders

Zahl tödlicher StreptokokkenInfektionen steigt

ObsgynWiki Streptokokken der Gruppe B
4.99 (266) NUMERO 6 – A house with a view – Lake Como, Italy. This wonderful 170m2 property dates back over 500 yrs. Arranged over three floors, its unique style combines the original features with beautifully designed modern bedrooms and bathrooms. Situated on the water front of Lake Como, the top floor opens out onto a spacious roof terrace.. Hoe kun je het voorkomen? Het oplopen van een GAS-infectie is lastig te voorkomen. Dit komt doordat de bacterie erg veel voorkomt en meestal geen klachten geeft. Je kunt wel de kans op een GAS-infectie verkleinen. Bijvoorbeeld door goede hygiëne toe te passen bij hoesten of niezen, en bij wondverzorging.

